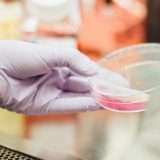

Samsung e il Ministero dell’Istruzione hanno annunciato l’inizio di Samsung School Labs, ossia la “fase 2” dell’iniziativa “LetsApp – Solve for Tomorrow Edition“. Il progetto è pensato per gli studenti delle scuole secondarie di secondo grado ed è finalizzato a sensibilizzare i giovani ad un diverso utilizzo del digitale.
LetsApp
600 i progetti proposti, 9 i gruppi finalisti scelti: per tutti è ora pronto un workshop (ovviamente da remoto) con il quale si forniranno agli studenti gli strumenti necessari per realizzare quanto immaginato. Dal 17 al 30 aprile la prima fase, quindi l’hackaton finale ed in fine la scelta della miglior idea entro maggio 2020.
Da quasi 30 anni, Samsung si impegna per la diffusione della cultura del digitale in Italia, contribuendo concretamente alla causa con diversi progetti formativi rivolti a diverse fasce della popolazione. Tra le iniziative rivolte ai più giovani spicca Samsung LetsApp, che negli ultimi tre anni, insieme ai nostri partner, ci ha permesso di offrire a tutti gli studenti italiani diverse tipologie di competenze, sia soft che digital skill, che si riveleranno sicuramente utili per la formazione professionale delle nuove generazioni. In questo contesto, siamo davvero entusiasti di avviare la fase School Labs della terza edizione di LetsApp, dopo aver accompagnato migliaia di studenti in tutta Italia durante il primo segmento del progetto attraverso un percorso formativo sul digitale, strutturato in 7 diversi moduli, nei quali sono stati alternate nozioni teoriche a demo pratiche
Anastasia Buda, Corporate Social Responsibility Manager di Samsung Electronics Italia
I 9 progetti finalisti
- Progetto “ArmillaR: Together to be safe” – Liceo Scientifico e Linguistico Ceccano, Ceccano (FR)
ArmillaR è un bracciale contenente un tag NFC in grado di memorizzare informazioni mediche e storia clinica dei pazienti, posizione dell’abitazione, numero di telefono e contatti di emergenza. - Progetto “Bio-ciclopedia” – I.I.S. Parentucelli Arzelà, Sarzana (SP)
Bio-ciclopedia è un’app con l’obbiettivo di rendere facilmente e velocemente accessibili informazioni riguardo al cibo che si acquista, attraverso la scannerizzazione del codice a barre posto sui prodotti. - Progetto “Financy” – I.T.S.T. “J.F. Kennedy”, Pordenone (PN)
Financy è un’applicazione che si rivolge ai giovani per avvicinarli alle tematiche finanziarie, ricca di corsi a tema, analisi di notizie in prospettiva economica, test e molto altro. - Progetto “Smart Parking Station” – I.I.S. “G.B. Vaccarini”, Catania (CT)
Smart Parking Station è un prototipo per la gestione di stazioni di rifornimento di ultima generazione ed ecologiche. Attraverso un’app e un sito dedicati si può localizzare la struttura più vicina, monitorare gli stalli disponibili e prenotare una postazione di ricarica. - Progetto “RIUS.CO.” – I.T.I. Volterra-Elia, Ancona (AN)
RIUS.CO è l’app per il RIUSo COllaborativo, un marketplace waste-free dove gli iscritti possono cercare e offrire oggetti che possono essere riutilizzati usando come moneta di scambio il Green Coin. - Progetto “Secchione” – I.I.S. “E. Fermi”, Sulmona (AQ)
Secchione è un sistema per gestire in maniera intelligente la raccolta differenziata, attraverso la scansione di un QR code che permette il corretto riciclaggio dei rifiuti, contabilizzato da un metodo di accumulo di punti convertibili in buoni sconto. - Progetto “Showtable” – I.I.S.S. “A. Pacinotti”, Taranto (TA)
Showtable è un tavolo interattivo pensato per soggetti che hanno patologie visive (es. maculopatie), bambini con difficoltà di apprendimento e persone anziane. Le varie tipologie di interazione vengono gestite da una app dedicata attraverso la tecnologia Bluetooth. - Progetto “Space Able. Il luogo capace di farti sognare” – I.S.I.S. Cipriano Facchinetti, Castellanza (VA)
Space Able è una app che permette a persone con disabilità motorie di controllare ambienti connessi, come una casa domotica o un ufficio, usando come controller il movimento della testa o dei propri occhi. - Progetto “SpreKapp” – I.T.S.C. “Salvatore Satta” (NU)
SpreKapp è una app che aiuta ad evitare gli spechi di cibo e farmaci attraverso il tracciamento dei prodotti dall’acquisto sino al loro consumo, attraverso il monitoraggio della scadenza.